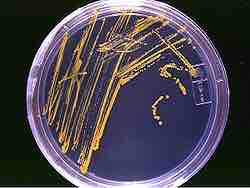

Antibiotics are produced industrially by a process of fermentation, where the source microorganism is grown in large containers (100,000 – 150,000 liters or more) containing a liquid growth medium.
Oxygen concentration, temperature, pH, and nutrient levels must be optimal and are closely monitored and adjusted if necessary. As antibiotics are secondary metabolites, the population size must be controlled very carefully to ensure that maximum yield is obtained before the cells die. Once the process is complete, the antibiotic must be extracted and purified to a crystalline product. This is simpler to achieve if the antibiotic is soluble in organic solvent. Otherwise it must first be removed by ion exchange, adsorption, or chemical precipitation.
Microorganisms used in fermentation are rarely identical to their counterparts in the wild. This is because species are often genetically modified to yield the maximum amounts of antibiotics. Mutation is often used and is encouraged by introducing mutagens such as ultraviolet radiation, x-rays, or certain chemicals. Selection and further reproduction of the higher yielding strains over many generations can raise yields by 20-fold or more. Another technique used to increase yields is gene amplification, where copies of genes coding for enzymes involved in the antibiotic production can be inserted back into a cell, via vectors such as plasmids. This process must be closely linked with retesting of antibiotic production and effectiveness.
An agar plate with microorganisms
This is an agar plate streaked with microorganisms.
Despite the wide variety of known antibiotics, less than 1% of antimicrobial agents have medical or commercial value. For example, whereas penicillin has a high therapeutic index as it does not generally affect human cells, this is not the case for many antibiotics. Other antibiotics simply lack advantage over those already in use or have no other practical applications.
Useful antibiotics are often discovered using a screening process. To conduct such a screen, isolates of many different microorganisms are cultured and then tested for production of diffusible products that inhibit the growth of test organisms. Most antibiotics identified in such a screen are already known and must therefore be disregarded. The remainder must be tested for their selective toxicities and therapeutic activities, and the best candidates can be examined and possibly modified.
A more modern version of this approach is a rational design program. This involves screening directed towards finding new natural products that inhibit a specific target, such as an enzyme only found in the target pathogen, rather than tests to show general inhibition of a culture.